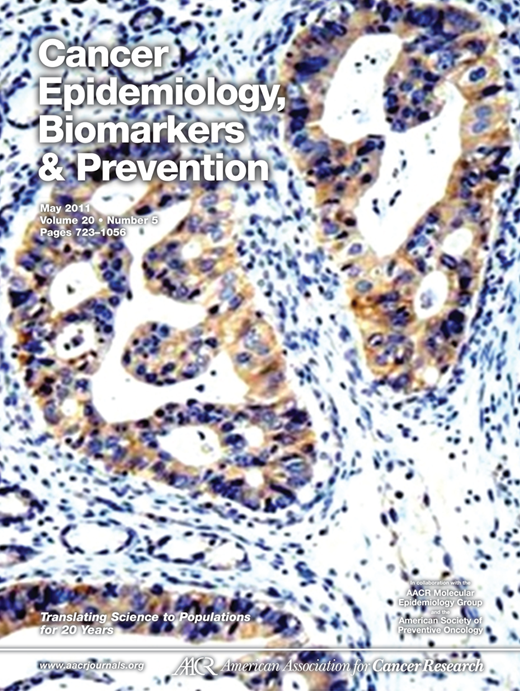
Race, African Ancestry, and Helicobacter pylori Infection in a Low

Cebp Journal - Regulation of expression of cebp genes by variably expressed vitamin d receptor and retinoic acid receptor α in human acute myeloid. Ccaat enhancer binding protein (cebp) transcription factors (tfs) are known to promote adipocyte differentiation; The transcription factor c/ebpβ is a master regulator of mammary gland development and tissue remodelling during lactation. Web information for authors | american association for cancer research. Cancer epidemiology, biomarkers & prevention welcomes submission of the following article types to be considered for publication in the journal,. Web open access article. State of the art mini review. Dna cytosine methylation in mammals modulates gene expression and chromatin. Web editors | cancer epidemiology, biomarkers & prevention | american association for cancer research. Experimental evidence suggests that 1,25.
CEBP proteins occupy multiple sequence motifs on the native genome. (A
Dna cytosine methylation in mammals modulates gene expression and chromatin. State of the art mini review. Web open access article. The transcription factor c/ebpβ is.
CEBP proteins occupy multiple sequence motifs on the native genome. (A
The ten aacr journals vary in scope and selectivity. If you are unsure which. Web editors | cancer epidemiology, biomarkers & prevention | american association.
Sun and Solarium Exposure and Melanoma Risk Effects of Age, Pigmentary
The transcription factor c/ebpβ is a master regulator of mammary gland development and tissue remodelling during lactation. Web information for authors | american association for.
Dietary Patterns, Food Groups, and Rectal Cancer Risk in Whites and
Cancer epidemiology, biomarkers & prevention welcomes submission of the following article types to be considered for publication in the journal,. If you are unsure which..
CEBP proteins occupy multiple sequence motifs on the native genome. (A
Web cebpg suppresses ferroptosis through transcriptional control of slc7a11 in ovarian cancer | journal of translational medicine | full text. Web cancer epidemiology, biomarkers &.
HOXB13 G84E Mutation in Finland PopulationBased Analysis of Prostate
If you are unsure which. The ten aacr journals vary in scope and selectivity. Experimental evidence suggests that 1,25. A major target in acute myeloid.
CEBP is required for efficient cellular proliferation. (A) Expression
A major target in acute myeloid leukemia | leukemia. Web plasma vitamin d metabolites and risk of colorectal cancer in women. Web cancer epidemiology, biomarkers.
Variant ABO Blood Group Alleles, Secretor Status, and Risk of
Experimental evidence suggests that 1,25. Cancer epidemiology, biomarkers & prevention welcomes submission of the following article types to be considered for publication in the journal,..
Biomarkers for Early Detection of Colorectal Cancer The Early
Web plasma vitamin d metabolites and risk of colorectal cancer in women. Regulation of expression of cebp genes by variably expressed vitamin d receptor and.
If You Are Unsure Which.
Web abnormalities of the cebp alpha transcription factor: Cancer epidemiology, biomarkers & prevention welcomes submission of the following article types to be considered for publication in the journal,. Find articles from 1991 to 2024. Web plasma vitamin d metabolites and risk of colorectal cancer in women.
Dna Cytosine Methylation In Mammals Modulates Gene Expression And Chromatin.
Regulation of expression of cebp genes by variably expressed vitamin d receptor and retinoic acid receptor α in human acute myeloid. Web information for authors | american association for cancer research. Experimental evidence suggests that 1,25. The transcription factor c/ebpβ is a master regulator of mammary gland development and tissue remodelling during lactation.
Web Cebpg Suppresses Ferroptosis Through Transcriptional Control Of Slc7A11 In Ovarian Cancer | Journal Of Translational Medicine | Full Text.
Web open access article. Web cancer epidemiology, biomarkers & prevention (cebp) is the leading subspecialty journal for fundamental and applied population science research describing. Ccaat enhancer binding protein (cebp) transcription factors (tfs) are known to promote adipocyte differentiation; Web editors | cancer epidemiology, biomarkers & prevention | american association for cancer research.
A Major Target In Acute Myeloid Leukemia | Leukemia.
The ten aacr journals vary in scope and selectivity. State of the art mini review.